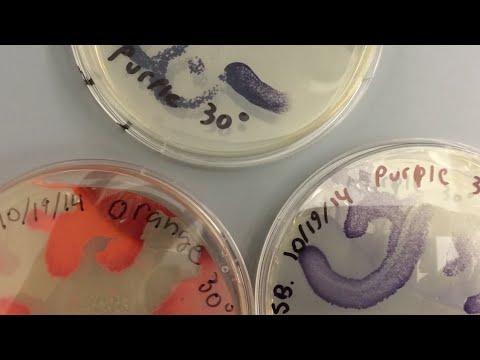
คลิกเพื่อดูคลิปวิดีโอ

Alexander Fleming มีชื่อเสียงเป็นที่รู้จักกันอย่างกว้างขวางว่า
เป็นนักจุลชีววิทยาผู้ยอดเยี่ยม ผู้ซึ่งมอบยารักษาโรค
ที่น่าอัศจรรย์ที่เรียกว่า ยาปฏิชีวนะ ให้กับชาวโลกจนทุกวันนี้
แต่ท่านยังมีผลงานด้านศิลปะที่คนทั่วไปไม่ค่อยรู้จักกันมากนัก
Alexander Fleming ยังเป็นสมาชิกของ
London’s Chelsea Arts Club
ซึ่งได้ทดลองสร้างผลงานฝีมือสมัครเล่นที่มีผลงานโด่งดังมากที่สุด
แต่ความสามารถทางด้านงานศิลปะของท่าน
ไม่ได้อยู่ที่ภาพวาดสีน้ำหรือภาพวาดด้วยดินสอ
แต่ท่านใช้สิ่งมีชีวิตอย่างอื่นแทน
Alexander Fleming คือ นักวิทยาศาสตร์คนแรก
ที่ใช้จุลินทรีย์เพื่อสร้างผลงานศิลปะในจานเลี้ยงเชื้อจุลินทรีย์
เช่น สุนัข นักมวย แม่เลี้ยงลูก นายทหาร
ผลงานศิลปะเหล่านี้ทำขึ้นโดยการเพาะเลี้ยงจุลินทรีย์
ที่มีสีธรรมชาติที่แตกต่างกันบนจานเพาะเลี้ยง
ในการสร้างลวดลายที่มีสีสันต้องใช้แบคทีเรียที่แตกต่างกัน
เพื่อให้สีต่าง ๆ เช่น สีน้ำตาล สีม่วง สีชมพู สีแดง สีเหลือง สีส้ม และสีอื่น ๆ
ด้วยจานเพาะเลี้ยงจุลินทรีย์ที่เติบโตขึ้นอย่างมาก
ในขณะที่ท่านค้นพบจุลินทรีย์ที่ขยายตัวมากขึ้นตามด้วยสีที่ต้องการ
Alexander Fleming จะเติมจานเพาะเชื้อด้วยวุ้นสารเจลาติน
แล้วใช้เครื่องมือในห้องปฏิบัติการที่เรียกว่า
Inoculation loop
เพื่อเขี่ยในจานเพาะเลี้ยงจุลินทรีย์สายพันธุ์ต่าง ๆ
ซึ่งเป็นเรื่องยากมากในทางเทคนิค/วิธีทำ
เพราะไม่เพียงแต่ต้องหาจุลินทรีย์ที่ถูกต้องเท่านั้น
แต่ยังต้องใช้เวลาในการใส่เชื้อ/เขี่ยเชื้อด้วย
เพื่อให้สายพันธุ์ต่าง ๆ มีสีเฉพาะตามที่ต้องการในเวลาเดียวกัน
งานสีเหล่านี้จะมีอยู่เพียงช่วงระยะเวลาสั้น ๆ ของวัน
หลังจากนั้นกลุ่มของจุลินทรีย์จะเติบโตในขนาดอื่น ๆ
และทำให้เส้น/ร่องรอยของภาพวาดพร่ามัวไป

บางส่วนของศิลปะการเพาะเลี้ยงโดย Alexander Fleming
แต่เป็นเรื่องที่น่าเสียดายสำหรับ Alexander Fleming
ที่ชุมชนนักวิทยาศาสตร์และศิลปินในยุคสมัยนั้น
ไม่ให้ความสนใจกับเทคนิคของท่าน
เรื่องนี้เคยเกิดขึ้นตอนที่ Alexander Fleming จัดนิทรรศการจุลินทรีย์ศิลป์ขนาดย่อม
เพื่อรับเสด็จ
Queen Mary ที่ทรงเยี่ยมเยียนโรงพยาบาล
St.Mary
แต่สมเด็จพระราชินี ไม่ทรงโปรดและเสด็จผ่านไปเลย
แม้ว่าท่านจะใช้จุลินทรีย์สร้างเป็นภาพธง
Union Jack
การสร้างสรรค์งานศิลปะของ Alexander Fleming
น่าจะมาจากความชอบพอกับการคบหากับพวกศิลปิน
ช่วงที่ท่านทำงานอยู่ที่โรงพยาบาล St.Mary
ผู้ป่วยหลายคนเป็นจิตรกรที่ต่างมารักษาโรคซิฟิลิส
Syphilis
และจิตรกรบางคนก็มอบภาพวาดให้กับท่าน
หรือบางคนก็แนะนำการวาดภาพให้กับท่าน เพื่อแลกเปลี่ยนกับค่ารักษา
ความชอบงานศิลปะของท่านจึงงอกงามขึ้นมาเรื่อย ๆ
ยิ่งเวลาผ่านไปยิ่งค้นพบจุลินทรีย์ที่ให้สีสันตามที่ต้องการได้
และท่านพบกับความสุขในการค้นพบสายพันธุ์ใหม่ ๆ ที่แปลกใหม่
เหมือนกับนักชีววิทยาภาคสนามที่อาจรู้สึกเหมือนกัน
ในสิ่งที่เกิดขึ้นใหม่และมหัศจรรย์บางอย่างของจุลินทรีย์
ท่านจึงรวบรวมสิ่งมีชีวิตที่ผิดปกติ
ด้วยความหวังว่า หนึ่งในนั้นอาจจะเป็นประโยชน์ในภายหน้า
Alexander Fleming เป็นศิลปินที่เรียนรู้ด้วยตนเอง
ไม่ได้ผ่านการฝึก/เรียนศิลปะอย่างแท้จริง
และท่านมักจะวาดภาพในสิ่งที่ท่านชื่นชอบ
มิติภาพจึงค่อนข้างน้อย/แตกต่างกันนิดหน่อย
แต่มีพลังสร้างสรรค์จากสิ่งมีชีวิตร่วมโลก
ที่อาศัยปะปนอยู่กับผู้คนที่ต่างต้องหายใจเข้าหายใจออก
และแล้วเช้าวันหนึ่งเป็นช่วงเวลาที่
Alexander Fleming ได้ค้นพบภาพวาดอย่างแท้จริง
แบคทีเรีย
Staphylococci แต่ละตัวที่ติดเชื้อบนจานนั้น
เติบโตขึ้นเป็นรูปร่างเล็ก ๆ คล้ายกับดาวเคราะห์/ดาวในท้องฟ้ายามราตรี
แต่ในหมู่ดาวเคราะห์มีอย่างอื่นที่มีขนาดใหญ่กว่า
และมีน้ำหนักเบากว่าอยู่ที่ด้านบนของจานเพาะเชื้อ
Penicillium เชื้อรา อยู่รอบท้องฟ้าที่ดำมืด
ในขณะที่พวกแบคทีเรียกำลังจะตาย
ผลงานชิ้นเอกของท่านคือ ดวงอาทิตย์ขึ้น
ภาพวาดที่ช่วยชีวิตผู้คนได้มากกว่าการค้นพบอื่น ๆ
ผลการค้นพบ
Penicillin สารประกอบที่ผลิตโดยเชื้อรา
ด้วยดวงตาในแบบของศิลปินซึ่งหายากในบรรดานักวิทยาศาสตร์ท่านอื่น ๆ
เพราะส่วนมากพวกท่านเคยเห็น
Penicillium
ที่เติบโตขึ้นมาในจานเพาะเชื้อก่อน Alexander Fleming
พวกท่านมักจะโยนจานเหล่านี้ทิ้งไปถือว่าเป็นความล้มเหลว
(ความจริงแล้ว ยาจีนและกรีก ต่างใช้เชื้อราเฉพาะ
เพื่อรักษาเชื้อแบคทีเรียเป็นเวลาหลายพันปีมาก่อนหน้านี้แล้ว)
แต่ที่ผ่านมา Alexander Fleming ใช้ชีวิตส่วนใหญ่เพื่อหาค่าสิ่งผิดปกติ
และสถานการณ์ที่เป็นที่ชื่นชอบของท่านทางด้านสีสันจากจุลินทรีย์
ค่าผิดปรกติที่พบไม่ใช่เรื่องที่โชคดี/ไม่ใช่อุบัติเหตุ
แต่เป็นเรื่องงานศิลป์ที่ท่านค้นพบเรื่องราวที่มีมีชีวิตชีวา
การค้นพบ Penicillin จึงไม่ใช่กรณีพิเศษแต่อย่างใด
การค้นพบเรื่องอื่น ๆ มาจากผลการสะสมองค์ความรู้อย่างยาวนาน
จากการรวบรวมข้อสังเกตแปลก ๆ ในจานเพาะเลี้ยงจุลินทรีย์
เช่นในวันหนึ่ง Alexander Fleming กำลังถือจานเพาะเลี้ยงจุลินทรีย์
ปรากฏว่าน้ำมูกของท่านหยดลงบนจานเพาะเลี้ยงเชื้อ
ท่านต้องการที่จะเห็นสิ่งที่จะเกิดขึ้นในเวลาต่อมา
ด้วยการสังเกตว่าอะไรจะเติบโตจากสิ่งแปลกปลอม สีใหม่หรือไม่
รูปแบบชีวิตใหม่จะเกิดขึ้นหรือไม่
แต่สิ่งที่พบก็คือ น้ำมูกของท่านฆ่าแบคทีเรียได้
นั่นคือ
Lysozyme ยาปฏิชีวนะตามธรรมชาติทั่วไป
ที่ร่างกายคนเราส่วนใหญ่ผลิตได้ในปริมาณมาก
Alexander Fleming มองข้ามเรื่องผิดปรกติไป
ด้วยการค้นหาสิ่งแปลกใหม่ในเรื่องที่คนอื่น ๆ ได้ทำสืบต่อกันมาในอดีต
เช่น การโยนทิ้งสิ่งที่น่ารังเกียจลงในถังขยะ/ทำลายทิ้งไปเลย

Alexander Fleming ในห้องปฏิบัติการของเขาที่ St Mary's, Paddington, London
เรียบเรียง/ที่มา
https://goo.gl/QHSbZv
https://goo.gl/C6c23y
https://goo.gl/6Y8NfS
งานศิลปะของจุลินทรีย์สมัยใหม่ที่มีการสร้างสรรค์มาก
ตัวอย่างงานศิลปะของจุลินทรีย์ที่ American Society of Microbiology
สำหรับการประกวดงานศิลปะ ASM Agar Art ประจำปี
New School Bacteria Painting Workshop
1.

2.

3.

4.

5.

6.

7.

8.

9.

10.

เรื่องเล่าไร้สาระ
Syphilis โรคแพทย์แผนไทยในอดีตเรียกว่า โรคเข้าข้อออกดอก
เกิดจากเชื้อแบคทีเรียชนิดหนึ่งที่เรียกว่า Treponema pallidum
มีตำนานเล่าว่า คนเลี้ยงแกะชายในอิตาลีสมสู่กับแกะตัวเมียเลยติดโรคนี้
แล้วแพร่กระจายโรคให้กับหญิงโสเภณีในนครรัฐเนเปิล อิตาลี
ทหารฝรั่งเศสเคยยึดเป็นเมืองขึ้นกว่า 3 ปีแล้วติดโรคนี้งอมแงม
จนมีชาวบ้านเรียกโรคนี้ว่า โรคฝรั่งเศส
แม้ว่า จะมีคนอ้างว่าโรคนี้ติดมากับชาวเรือสเปน
ที่ไปยึดครองโลกใหม่ในละตินอเมริกา
แล้วติดโรคนี้จากสตรีพื้นเมืองชนเผ่าที่ไปยึดครอง
ก่อนหน้าที่จะมาระบาดในอิตาลี
แต่ก็ไม่มีหลักฐานที่ชัดเจน
เหมือนบันทึกการติดโรคของทหารฝรั่งเศส
โรคนี้แพร่ระบาดจากนักเดินเรือชาย
ที่ไปแวะตามเมืองท่าต่าง ๆ แล้วมีเพศสัมพันธ์ุกับหญิงโสเภณี
แล้วส่งผ่านส่งต่อกันเป็นทอด ๆ ทั้งหญิงกับชายที่ติดโรคนี้จนกระจายไปทั่วโลก
อาการเข้าข้ออกดอกเป็นอาการระยะที่สองและสามของโรคนี้
ที่เชื้อกระจายออกมา ทำให้ปวดข้อ เข้าสมองและเกิดผื่นตามร่างกาย
ในสมัยที่สยามยังไม่มียาปฏิชีวนะเพนนิซิลินที่ Alexandre Flemming ค้นพบในการรักษา
ยาไทยก็มักจะใช้พวกข้าวเย็นเหนือ ข้าวเย็นใต้ เป็นตัวยาหลัก
ผสมกับสมุนไพรต่าง ๆ ตามสูตรคิดค้นของหมอไทยแผนโบราณ
แบบรักษาทุเลาอาการมากกว่าเพราะส่วนมากมักจะตาย
อาการของโรคที่น่าสยดสยองนี้
ทำให้เป็นส่วนหนึ่งของฉากหนังไทยจำนวนหลายเรื่อง
ที่แสดงถึงตัวร้ายผู้หญิงผู้ชายที่ในตอนจบมักจะรับกรรมจากโรคนี้
มีบุคคลที่หายสาบสูญไปจากหน้าประวัติศาตร์คือ
คะนัง เด็กชายเงาะป่า/เซมังซาไก
ที่พระปิยะมหาราชทรงนำมาชุบเลี้ยง
หลังจากพระองค์เสด็จสวรรคต
คะนังก็กลายเป็นเด็กวัยรุ่นที่ถูกปล่อยวาง
ไม่มีคนในวังสนใจใยดี เพราะถือว่าเป็นคนไร้มารยา
คะนังกลายเป็นคนก้าวร้าว ไม่มีใครอยากยุ่งด้วย
ทั้งยังมีนิสัยชอบกินเหล้าเมายามั่วสุมกับหญิงโสเภณี
สุดท้ายตายด้วยโรคเข้าข้อออกดอก
และมีการเผาศพที่วัดแห่งหนึ่งแบบศพคนไร้ญาติ
ตามบันทึกที่เคยอ่านเจอนานแล้ว
Alexander Fleming ผู้ริเริ่มจุลินทรีย์ศิลป์
Alexander Fleming มีชื่อเสียงเป็นที่รู้จักกันอย่างกว้างขวางว่า
เป็นนักจุลชีววิทยาผู้ยอดเยี่ยม ผู้ซึ่งมอบยารักษาโรค
ที่น่าอัศจรรย์ที่เรียกว่า ยาปฏิชีวนะ ให้กับชาวโลกจนทุกวันนี้
แต่ท่านยังมีผลงานด้านศิลปะที่คนทั่วไปไม่ค่อยรู้จักกันมากนัก
Alexander Fleming ยังเป็นสมาชิกของ London’s Chelsea Arts Club
ซึ่งได้ทดลองสร้างผลงานฝีมือสมัครเล่นที่มีผลงานโด่งดังมากที่สุด
แต่ความสามารถทางด้านงานศิลปะของท่าน
ไม่ได้อยู่ที่ภาพวาดสีน้ำหรือภาพวาดด้วยดินสอ
แต่ท่านใช้สิ่งมีชีวิตอย่างอื่นแทน
Alexander Fleming คือ นักวิทยาศาสตร์คนแรก
ที่ใช้จุลินทรีย์เพื่อสร้างผลงานศิลปะในจานเลี้ยงเชื้อจุลินทรีย์
เช่น สุนัข นักมวย แม่เลี้ยงลูก นายทหาร
ผลงานศิลปะเหล่านี้ทำขึ้นโดยการเพาะเลี้ยงจุลินทรีย์
ที่มีสีธรรมชาติที่แตกต่างกันบนจานเพาะเลี้ยง
ในการสร้างลวดลายที่มีสีสันต้องใช้แบคทีเรียที่แตกต่างกัน
เพื่อให้สีต่าง ๆ เช่น สีน้ำตาล สีม่วง สีชมพู สีแดง สีเหลือง สีส้ม และสีอื่น ๆ
ด้วยจานเพาะเลี้ยงจุลินทรีย์ที่เติบโตขึ้นอย่างมาก
ในขณะที่ท่านค้นพบจุลินทรีย์ที่ขยายตัวมากขึ้นตามด้วยสีที่ต้องการ
Alexander Fleming จะเติมจานเพาะเชื้อด้วยวุ้นสารเจลาติน
แล้วใช้เครื่องมือในห้องปฏิบัติการที่เรียกว่า Inoculation loop
เพื่อเขี่ยในจานเพาะเลี้ยงจุลินทรีย์สายพันธุ์ต่าง ๆ
ซึ่งเป็นเรื่องยากมากในทางเทคนิค/วิธีทำ
เพราะไม่เพียงแต่ต้องหาจุลินทรีย์ที่ถูกต้องเท่านั้น
แต่ยังต้องใช้เวลาในการใส่เชื้อ/เขี่ยเชื้อด้วย
เพื่อให้สายพันธุ์ต่าง ๆ มีสีเฉพาะตามที่ต้องการในเวลาเดียวกัน
งานสีเหล่านี้จะมีอยู่เพียงช่วงระยะเวลาสั้น ๆ ของวัน
หลังจากนั้นกลุ่มของจุลินทรีย์จะเติบโตในขนาดอื่น ๆ
และทำให้เส้น/ร่องรอยของภาพวาดพร่ามัวไป
บางส่วนของศิลปะการเพาะเลี้ยงโดย Alexander Fleming
แต่เป็นเรื่องที่น่าเสียดายสำหรับ Alexander Fleming
ที่ชุมชนนักวิทยาศาสตร์และศิลปินในยุคสมัยนั้น
ไม่ให้ความสนใจกับเทคนิคของท่าน
เรื่องนี้เคยเกิดขึ้นตอนที่ Alexander Fleming จัดนิทรรศการจุลินทรีย์ศิลป์ขนาดย่อม
เพื่อรับเสด็จ Queen Mary ที่ทรงเยี่ยมเยียนโรงพยาบาล St.Mary
แต่สมเด็จพระราชินี ไม่ทรงโปรดและเสด็จผ่านไปเลย
แม้ว่าท่านจะใช้จุลินทรีย์สร้างเป็นภาพธง Union Jack
การสร้างสรรค์งานศิลปะของ Alexander Fleming
น่าจะมาจากความชอบพอกับการคบหากับพวกศิลปิน
ช่วงที่ท่านทำงานอยู่ที่โรงพยาบาล St.Mary
ผู้ป่วยหลายคนเป็นจิตรกรที่ต่างมารักษาโรคซิฟิลิส Syphilis
และจิตรกรบางคนก็มอบภาพวาดให้กับท่าน
หรือบางคนก็แนะนำการวาดภาพให้กับท่าน เพื่อแลกเปลี่ยนกับค่ารักษา
ความชอบงานศิลปะของท่านจึงงอกงามขึ้นมาเรื่อย ๆ
ยิ่งเวลาผ่านไปยิ่งค้นพบจุลินทรีย์ที่ให้สีสันตามที่ต้องการได้
และท่านพบกับความสุขในการค้นพบสายพันธุ์ใหม่ ๆ ที่แปลกใหม่
เหมือนกับนักชีววิทยาภาคสนามที่อาจรู้สึกเหมือนกัน
ในสิ่งที่เกิดขึ้นใหม่และมหัศจรรย์บางอย่างของจุลินทรีย์
ท่านจึงรวบรวมสิ่งมีชีวิตที่ผิดปกติ
ด้วยความหวังว่า หนึ่งในนั้นอาจจะเป็นประโยชน์ในภายหน้า
Alexander Fleming เป็นศิลปินที่เรียนรู้ด้วยตนเอง
ไม่ได้ผ่านการฝึก/เรียนศิลปะอย่างแท้จริง
และท่านมักจะวาดภาพในสิ่งที่ท่านชื่นชอบ
มิติภาพจึงค่อนข้างน้อย/แตกต่างกันนิดหน่อย
แต่มีพลังสร้างสรรค์จากสิ่งมีชีวิตร่วมโลก
ที่อาศัยปะปนอยู่กับผู้คนที่ต่างต้องหายใจเข้าหายใจออก
และแล้วเช้าวันหนึ่งเป็นช่วงเวลาที่
Alexander Fleming ได้ค้นพบภาพวาดอย่างแท้จริง
แบคทีเรีย Staphylococci แต่ละตัวที่ติดเชื้อบนจานนั้น
เติบโตขึ้นเป็นรูปร่างเล็ก ๆ คล้ายกับดาวเคราะห์/ดาวในท้องฟ้ายามราตรี
แต่ในหมู่ดาวเคราะห์มีอย่างอื่นที่มีขนาดใหญ่กว่า
และมีน้ำหนักเบากว่าอยู่ที่ด้านบนของจานเพาะเชื้อ
Penicillium เชื้อรา อยู่รอบท้องฟ้าที่ดำมืด
ในขณะที่พวกแบคทีเรียกำลังจะตาย
ผลงานชิ้นเอกของท่านคือ ดวงอาทิตย์ขึ้น
ภาพวาดที่ช่วยชีวิตผู้คนได้มากกว่าการค้นพบอื่น ๆ
ผลการค้นพบ Penicillin สารประกอบที่ผลิตโดยเชื้อรา
ด้วยดวงตาในแบบของศิลปินซึ่งหายากในบรรดานักวิทยาศาสตร์ท่านอื่น ๆ
เพราะส่วนมากพวกท่านเคยเห็น Penicillium
ที่เติบโตขึ้นมาในจานเพาะเชื้อก่อน Alexander Fleming
พวกท่านมักจะโยนจานเหล่านี้ทิ้งไปถือว่าเป็นความล้มเหลว
(ความจริงแล้ว ยาจีนและกรีก ต่างใช้เชื้อราเฉพาะ
เพื่อรักษาเชื้อแบคทีเรียเป็นเวลาหลายพันปีมาก่อนหน้านี้แล้ว)
แต่ที่ผ่านมา Alexander Fleming ใช้ชีวิตส่วนใหญ่เพื่อหาค่าสิ่งผิดปกติ
และสถานการณ์ที่เป็นที่ชื่นชอบของท่านทางด้านสีสันจากจุลินทรีย์
ค่าผิดปรกติที่พบไม่ใช่เรื่องที่โชคดี/ไม่ใช่อุบัติเหตุ
แต่เป็นเรื่องงานศิลป์ที่ท่านค้นพบเรื่องราวที่มีมีชีวิตชีวา
การค้นพบ Penicillin จึงไม่ใช่กรณีพิเศษแต่อย่างใด
การค้นพบเรื่องอื่น ๆ มาจากผลการสะสมองค์ความรู้อย่างยาวนาน
จากการรวบรวมข้อสังเกตแปลก ๆ ในจานเพาะเลี้ยงจุลินทรีย์
เช่นในวันหนึ่ง Alexander Fleming กำลังถือจานเพาะเลี้ยงจุลินทรีย์
ปรากฏว่าน้ำมูกของท่านหยดลงบนจานเพาะเลี้ยงเชื้อ
ท่านต้องการที่จะเห็นสิ่งที่จะเกิดขึ้นในเวลาต่อมา
ด้วยการสังเกตว่าอะไรจะเติบโตจากสิ่งแปลกปลอม สีใหม่หรือไม่
รูปแบบชีวิตใหม่จะเกิดขึ้นหรือไม่
แต่สิ่งที่พบก็คือ น้ำมูกของท่านฆ่าแบคทีเรียได้
นั่นคือ Lysozyme ยาปฏิชีวนะตามธรรมชาติทั่วไป
ที่ร่างกายคนเราส่วนใหญ่ผลิตได้ในปริมาณมาก
Alexander Fleming มองข้ามเรื่องผิดปรกติไป
ด้วยการค้นหาสิ่งแปลกใหม่ในเรื่องที่คนอื่น ๆ ได้ทำสืบต่อกันมาในอดีต
เช่น การโยนทิ้งสิ่งที่น่ารังเกียจลงในถังขยะ/ทำลายทิ้งไปเลย
Alexander Fleming ในห้องปฏิบัติการของเขาที่ St Mary's, Paddington, London
เรียบเรียง/ที่มา
https://goo.gl/QHSbZv
https://goo.gl/C6c23y
https://goo.gl/6Y8NfS
งานศิลปะของจุลินทรีย์สมัยใหม่ที่มีการสร้างสรรค์มาก
ตัวอย่างงานศิลปะของจุลินทรีย์ที่ American Society of Microbiology
สำหรับการประกวดงานศิลปะ ASM Agar Art ประจำปี
New School Bacteria Painting Workshop
1.
2.
3.
4.
5.
6.
7.
8.
9.
10.
เรื่องเล่าไร้สาระ
Syphilis โรคแพทย์แผนไทยในอดีตเรียกว่า โรคเข้าข้อออกดอก
เกิดจากเชื้อแบคทีเรียชนิดหนึ่งที่เรียกว่า Treponema pallidum
มีตำนานเล่าว่า คนเลี้ยงแกะชายในอิตาลีสมสู่กับแกะตัวเมียเลยติดโรคนี้
แล้วแพร่กระจายโรคให้กับหญิงโสเภณีในนครรัฐเนเปิล อิตาลี
ทหารฝรั่งเศสเคยยึดเป็นเมืองขึ้นกว่า 3 ปีแล้วติดโรคนี้งอมแงม
จนมีชาวบ้านเรียกโรคนี้ว่า โรคฝรั่งเศส
แม้ว่า จะมีคนอ้างว่าโรคนี้ติดมากับชาวเรือสเปน
ที่ไปยึดครองโลกใหม่ในละตินอเมริกา
แล้วติดโรคนี้จากสตรีพื้นเมืองชนเผ่าที่ไปยึดครอง
ก่อนหน้าที่จะมาระบาดในอิตาลี
แต่ก็ไม่มีหลักฐานที่ชัดเจน
เหมือนบันทึกการติดโรคของทหารฝรั่งเศส
โรคนี้แพร่ระบาดจากนักเดินเรือชาย
ที่ไปแวะตามเมืองท่าต่าง ๆ แล้วมีเพศสัมพันธ์ุกับหญิงโสเภณี
แล้วส่งผ่านส่งต่อกันเป็นทอด ๆ ทั้งหญิงกับชายที่ติดโรคนี้จนกระจายไปทั่วโลก
อาการเข้าข้ออกดอกเป็นอาการระยะที่สองและสามของโรคนี้
ที่เชื้อกระจายออกมา ทำให้ปวดข้อ เข้าสมองและเกิดผื่นตามร่างกาย
ในสมัยที่สยามยังไม่มียาปฏิชีวนะเพนนิซิลินที่ Alexandre Flemming ค้นพบในการรักษา
ยาไทยก็มักจะใช้พวกข้าวเย็นเหนือ ข้าวเย็นใต้ เป็นตัวยาหลัก
ผสมกับสมุนไพรต่าง ๆ ตามสูตรคิดค้นของหมอไทยแผนโบราณ
แบบรักษาทุเลาอาการมากกว่าเพราะส่วนมากมักจะตาย
อาการของโรคที่น่าสยดสยองนี้
ทำให้เป็นส่วนหนึ่งของฉากหนังไทยจำนวนหลายเรื่อง
ที่แสดงถึงตัวร้ายผู้หญิงผู้ชายที่ในตอนจบมักจะรับกรรมจากโรคนี้
มีบุคคลที่หายสาบสูญไปจากหน้าประวัติศาตร์คือ
คะนัง เด็กชายเงาะป่า/เซมังซาไก
ที่พระปิยะมหาราชทรงนำมาชุบเลี้ยง
หลังจากพระองค์เสด็จสวรรคต
คะนังก็กลายเป็นเด็กวัยรุ่นที่ถูกปล่อยวาง
ไม่มีคนในวังสนใจใยดี เพราะถือว่าเป็นคนไร้มารยา
คะนังกลายเป็นคนก้าวร้าว ไม่มีใครอยากยุ่งด้วย
ทั้งยังมีนิสัยชอบกินเหล้าเมายามั่วสุมกับหญิงโสเภณี
สุดท้ายตายด้วยโรคเข้าข้อออกดอก
และมีการเผาศพที่วัดแห่งหนึ่งแบบศพคนไร้ญาติ
ตามบันทึกที่เคยอ่านเจอนานแล้ว